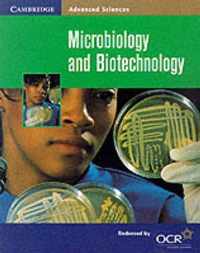

cambridge introductions to philosophy and biology online kopen
Ben je op zoek naar cambridge introductions to philosophy and biology? Bekijk onze boeken selectie en zie direct bij welke webshop je cambridge introductions to philosophy and biology online kan kopen. Ga je voor een ebook of paperback van cambridge introductions to philosophy and biology. Zoek ook naar accesoires voor cambridge introductions to philosophy and biology. Zo ben je er helemaal klaar voor. Ontdek ook andere producten en koop vandaag nog je cambridge introductions to philosophy and biology met korting of in de aanbieding. Alles voor veel leesplezier!
Philosophy of Biology
By combining excerpts from key historical writings with editors' introductions and further reading material, Philosophy of Biology: An;
Vergelijkbare producten zoals Philosophy of Biology
Philosophy of Biology
By combining excerpts from key historical writings with editors' introductions and further reading material, Philosophy of Biology: An;
Vergelijkbare producten zoals Philosophy of Biology
The Individual in the Animal Kingdom
text contains an interdisciplinary discussion of individuality in nature, taking influence from both biology and philosophy.;
Vergelijkbare producten zoals The Individual in the Animal Kingdom
Cambridge Introductions to Philosophy and Biology
the reader to exciting recent work in the philosophy of paleontology and to theoretical issues including punctuated equilibria and species;
Vergelijkbare producten zoals Cambridge Introductions to Philosophy and Biology
Cambridge Introductions to Philosophy and Biology
the reader to exciting recent work in the philosophy of paleontology and to theoretical issues including punctuated equilibria and species;
Vergelijkbare producten zoals Cambridge Introductions to Philosophy and Biology
Cambridge Studies in Philosophy and Biology
intersection of biology and epistemology. It asks whether the study of life requires a special biological approach to knowledge and concludes that it;
Vergelijkbare producten zoals Cambridge Studies in Philosophy and Biology
Cambridge Studies in Philosophy and Biology
intersection of biology and epistemology. It asks whether the study of life requires a special biological approach to knowledge and concludes that it;
Vergelijkbare producten zoals Cambridge Studies in Philosophy and Biology
Cambridge O Level Biology
enable the learner to effectively navigate through the content of the revised Cambridge O Level Biology (5090) syllabus for examination from 2023;
Vergelijkbare producten zoals Cambridge O Level Biology
Complete Biology for Cambridge Lower Secondary
stage to the next. Regular revision and extension exercises will help consolidate learning and then stretch and challenge students to reach the;
Vergelijkbare producten zoals Complete Biology for Cambridge Lower Secondary
Cambridge Introductions to Philosophy
What is philosophy? How should we do it? Why should we bother to? These are the kinds of questions addressed by metaphilosophy - the;
Vergelijkbare producten zoals Cambridge Introductions to Philosophy
Cambridge Introductions to Philosophy
What is philosophy? How should we do it? Why should we bother to? These are the kinds of questions addressed by metaphilosophy - the;
Vergelijkbare producten zoals Cambridge Introductions to Philosophy
Cambridge IGCSE (TM) Biology 4th Edition
questions to put these skills into practice. - Consolidate skills and check understanding: self-assessment questions covering core and supplement;
Vergelijkbare producten zoals Cambridge IGCSE (TM) Biology 4th Edition
Microbiology and Biotechnology
specifications for Advanced Level Biology for teaching from September 2000. Microbiology and Biotechnology has been endorsed by OCR for use with the OCR;
Vergelijkbare producten zoals Microbiology and Biotechnology
Cambridge Introductions to Key Philosophical Texts
predecessors and to contemporary debates, explaining his Critical philosophy as a response to the failure of rationalism and the challenge;
Vergelijkbare producten zoals Cambridge Introductions to Key Philosophical Texts
Cambridge Introductions to Philosophy
In this book Jonathan Lowe offers a lucid and wide-ranging introduction to the philosophy of mind. Using a problem-centred approach;
Vergelijkbare producten zoals Cambridge Introductions to Philosophy
Cambridge Studies in Philosophy and Biology
, accessible style this collection should appeal to students and professionals in philosophy of science, and the philosophy and history of biology.;
Vergelijkbare producten zoals Cambridge Studies in Philosophy and Biology
Cambridge Studies in Philosophy and Biology
, accessible style this collection should appeal to students and professionals in philosophy of science, and the philosophy and history of biology.;
Vergelijkbare producten zoals Cambridge Studies in Philosophy and Biology
Cambridge Studies in Philosophy and Biology
that biology and logic may be intimately interrelated. In this book, William Cooper outlines a theory of rationality in which logical law;
Vergelijkbare producten zoals Cambridge Studies in Philosophy and Biology
Cambridge Studies in Philosophy and Biology
the progress of science. This book will appeal to students and professional in the philosophy of science, the philosophy of biology and the;
Vergelijkbare producten zoals Cambridge Studies in Philosophy and Biology
Cambridge Studies in Philosophy and Biology
the progress of science. This book will appeal to students and professional in the philosophy of science, the philosophy of biology and the;
Vergelijkbare producten zoals Cambridge Studies in Philosophy and Biology
Essential Biology for Cambridge Lower Secondary Stage 9 Workbook
curriculum. The Workbook is written by an experienced author team and supports and supplements the Stage 9 Biology Student Book. It contains;
Vergelijkbare producten zoals Essential Biology for Cambridge Lower Secondary Stage 9 Workbook
Cambridge Studies in Philosophy and Biology
relation of biology and ethics, and has been written by some of the leading figures in the history and philosophy of science, whose work stands;
Vergelijkbare producten zoals Cambridge Studies in Philosophy and Biology
Cambridge O Level Biology Revision Guide
Revision Guide to support students of Cambridge O Level Biology through their course and help them to prepare for assessment. The Cambridge;
Vergelijkbare producten zoals Cambridge O Level Biology Revision Guide
The Cambridge Companion to Aristotle's Biology
as nutrition, reproduction, perception and self-motion, in his philosophy. The importance of Aristotle's zoology to both his ethics and;
Vergelijkbare producten zoals The Cambridge Companion to Aristotle's Biology
The Cambridge Companion to Aristotle's Biology
as nutrition, reproduction, perception and self-motion, in his philosophy. The importance of Aristotle's zoology to both his ethics and;
Vergelijkbare producten zoals The Cambridge Companion to Aristotle's Biology
Growth, Development and Reproduction
new specifications for Advanced Level Biology for teaching from September 2000. Growth, Development and Reproduction has been endorsed by OCR;
Vergelijkbare producten zoals Growth, Development and Reproduction
Einde inhoud
Geen pagina's meer om te laden'